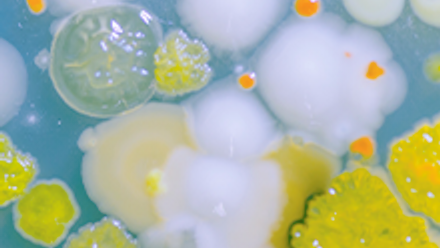
Microbial evolution 220x220.png

British Yeast Group 2022 - poster prize winners
Over the three days at British Yeast Group 2022, delegates showcased their research and excellent posters. Our flagship journal, Microbiology, sponsored the Best Science Poster Prize and is pleased to announce the winner selected by members of the organising committee:
- Sofia Esteban Serna, University of Edinburgh, UK who won for the poster titled, 'A Co-transcriptional Regulatory Mechanism Tightly Controls Gene Expression during Stress in Budding Yeast'.
The Carl Singer Foundation sponsored the Flash Poster Presentation session in which presenters were tasked with a secret objective during their talk. We are pleased to share the two winners who received a cash prize for their presentations:
- Matthew Shaw, University of Kent, 'Using CRISPR-Cas9 to study the evolutionary role of genome instability in Candida albicans'
- Jason Yu, The Francis Crick Institute, 'Resolving a metabolic paradox - Inorganic sulfur fixation via a new homocysteine synthase allows yeast to cooperatively compensate for methionine auxotrophy'
The winners, will win a cash prize and be featured on the Microbe Post.
Congratulations to the poster prize winners and thank you to all the poster presenters!
Image: Scott Curran